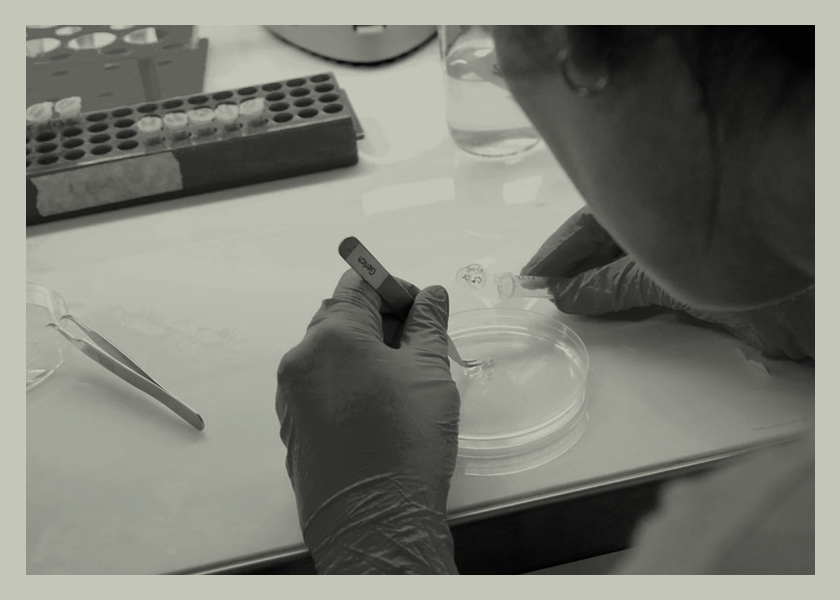

- Locales
- Locales
precaución
EconomiaNacionalesOtrosPolíticaSociedadEl DNU de Javier Milei deroga la ley de abastecimiento, ley de góndolas y Compre Argentino
La ley de góndolas y Compre Argentino son herramientas fundamentales para traccionar desarrollo local y las pyme. La ley de abastecimiento fue...
By La Ciudad22/12/2023EconomiaNacionalesNovedadesOtrosOtrosPolíticaSociedadTecnologíaEl robo de criptomonedas alcanzó un récord de US$ 3.800 millones en 2022
Los robos y hackeos de criptomonedas en todo el mundo marcaron un récord en 2022, luego de que cerca de US$ 3.800 millones...
By La Ciudad05/02/2023LocalesSeguridad VialSocialesSociedadPARA CONOCIMIENTO DE LOS AUTOMOVILISTAS: SIN SEMÁFORO
Por la tarde de ayer viernes dos camiones dejaron sin funcionamiento el semáforo de El Despertar del Obrero y Acceso Bruno. Por tal...
By La Ciudad22/10/2022LocalesPolíticaSociedadPiden precaución al pasar por la zona de Defensa Norte. Caminos alternativos para ir a Pelay y Paso Vera
La temporada de verano y el acceso a las playas motiva el paso de muchas personas. La Unidad Transitoria de Empresas (UTE), constituida...
By La Ciudad15/01/2021ProvincialesSociedadMangas de langostas ingresó este domingo al norte entrerriano
La manga de langostas que en las últimas semanas había puesto en alerta al sur de Corrientes, ingresó en la tarde de este...
By La Ciudad21/07/2020EducaciónFamiliaInterés GeneralNacionalesPolíticaSaludSeguridad VialSociedadGuía de primeros auxilios para niños ante accidentes en la calle
A pesar de haberse cambiado las tornas y de que nuestras ciudades se vuelven cada vez más seguras, los accidentes son uno de los...
By La Ciudad13/07/2020Interés GeneralSaludCoronavirus: ciencia vs paranoia
Te compartimos una serie de recomendaciones para combatir eficazmente al coronavirus y evitar la paranoia. Periodistas discuten con uno de los infectólogos...
By La Ciudad12/03/2020
- Locales